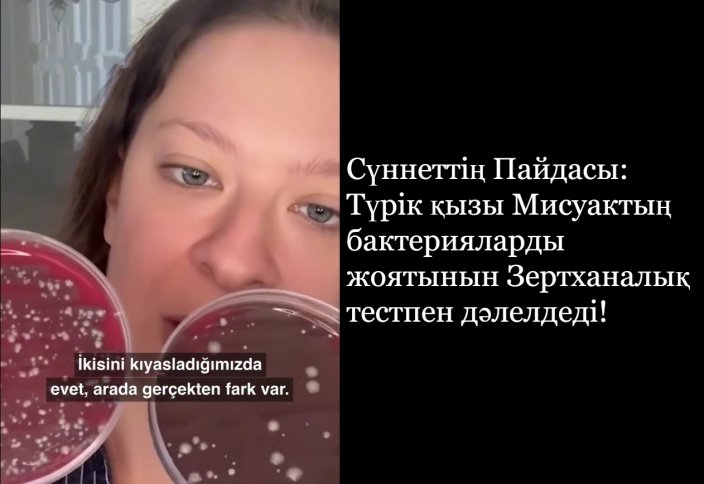
Генетика саласының маманы Мисуактың антибактериалды қасиетін анықтады

Ардақты Пайғамбарымыз Мұхаммедтің (оған Алланың игілігі мен сәлемі болсын) қай сүннеті мен өсиетін алсақ та, оның астарында пенде үшін зор пайда мен өмірлік даналық жатқанын ұғынамыз. Тіпті, болашақтан хабар берген хадистерінің көбі бүгінгі таңда жүзеге асып, оған күнделікті өмірде куә болып жүрміз. Бұл жайттар Алла Тағаланың Құран Кәрімдегі: «Ол (Мұхаммед) өз ойынан сөйлемейді. Оның сөйлегені – тек уахи ғана» («Нәжм» сүресі, 3-4 аяттар) деген сөзін тағы бір дәлелдей түседі.
Сол сүннеттердің бірі – тісті мисуакпен тазалау.
Жақында Түркия елінің генетика саласының маманы Дилара Сары Мисуактың тістегі бактерияларды қалай жоятынын көрсететін зертханалық тәжірибе жүргізді. Бұл тәжірибе мисуактың пайдасы туралы бұрыннан айтылып жүрген деректерге қосымша ғылыми дәлел болып отыр.
Видеода зерттеу барысы анық көрсетілген (видео*). Генетик маман алдымен тазаланбаған тістен сынама алып, оны арнайы ыдысқа салады. Содан соң тісін мисуакпен ысқылап, одан кейінгі екінші сынаманы басқа ыдысқа орналастырады. Зертханалық нәтижелер мисуак қолданбаған бірінші сынамада бактериялардың қаптап тұрғанын, ал мисуакпен тазаланған екінші сынамада зиянды микроорганизмдердің едәуір азайғанын айқын көрсетті.
Бұл – Алла Елшісінің (оған Алланың игілігі мен сәлемі болсын) неліктен тісті мисуакпен тазалауға үнемі үндегенінің бір дәлелі. Ол бір хадисінде: «Үмбетіме (немесе адамдарға) ауыр келеді деп қорықпасам, әр намаздың алдында мисуакпен тістерін тазалауды бұйырар едім», – деген. Басқа бір риуаятта «әр дәреттің алдында» деп те келтіріледі («Сахих әл-Бұхари», «Сахих Муслим»).
Пайғамбарымыз (оған Алланың игілігі мен сәлемі болсын) бұл өсиетін өзі де үнемі орындап өткен. Тіпті, өмірінің соңғы сәтінде, қатты науқастанып, сөйлеуге шамасы келмей жатқанда да мисуакқа қараған екен. Мұны бірден түсінген жұбайы Айша анамыз (оған Алла разы болсын) мисуактың ұшын шайнап, жұмсартып, Пайғамбарымызға ұстатады. Алла Елшісі тісін жақсылап тазалағаннан кейін көп ұзамай көз жұмған. Әлемдерге рақым нұры болып жіберілген соңғы Пайғамбардың ақтық демінде де тіс тазалығына мән беруі – ауыз қуысы гигиенасының дінімізде қаншалықты маңызды екенін көрсетеді.
Мұсылман үмбеті он төрт ғасырдан бері осы маңызды сүннетті орындап келеді. Ал бүгінгі ғылым оның денсаулыққа пайдасын енді ғана толық дәлелдеп жатыр. Бұл жайт Алла Елшісінің әрбір сүннетінің астарында пенде үшін зор пайда жатқанын тағы бір рет айғақтайды.
Мисуактың бактерияларды қалай жоятынын ғылыми тұрғыдан көру – Алла Елшісінің қасиетті сүннеттеріне деген сенімімізді одан сайын арттыруда. Бізді Ислам нығметіне бөлеген Аллаға сансыз шүкірлер болсын! Әлхамдулилләһи Раббиль аләмин!